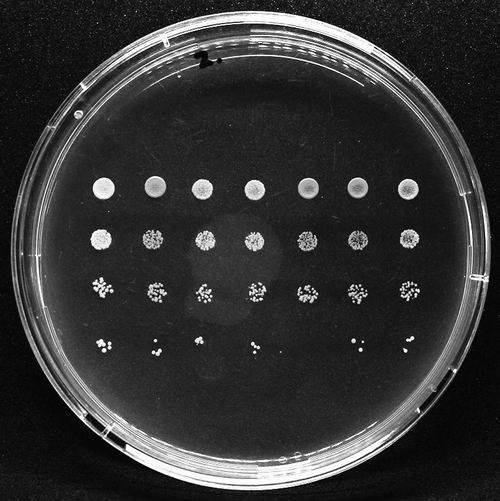

著名的疯牛病由朊病毒引起。此类朊病毒病不仅影响动物,还会严重危害人体健康。美国研究人员近日报告称,他们首次人工合成了人类朊病毒,对了解该病毒的结构和复制方式、研发治疗方法具有重要意义。
朊病毒的本质是蛋白质。人和一些动物中枢神经系统中的蛋白质如果发生折叠错误,就会形成具有传染性质的朊病毒。它们在大脑中与邻近的正常蛋白质不断结合,使脑部出现海绵状空洞,引发脑功能退化、痴呆等症状,最终可致死亡。
此前研究人员能从啮齿类动物身上提取数种朊病毒,但小鼠实验显示,这些朊病毒对人类不具传染性,且结构和复制方式也不同于人类朊病毒。
美国凯斯西保留地大学研究人员利用基因技术改造大肠杆菌,使其能产生人类朊病毒,最终得到一种新的、具有高度破坏性的人类朊病毒。
凯斯西保留地大学医学院教授伊里·萨法尔说:“这项成果代表一个分水岭。此前我们对大脑中朊病毒的认识有限。能在试管中合成人类朊病毒,将使我们对其结构和复制方式有更深入的了解,这对开发抑制剂至关重要。”
研究人员还发现了一种与朊病毒病有关的辅助因子:神经节苷脂GM1。它在细胞间信号传递中起调节作用,能触发朊病毒的传播。这一发现有助于找到抗击朊病毒病的新方法。
相关论文近日发表在英国《自然—通讯》杂志上。
来源:中国科学报